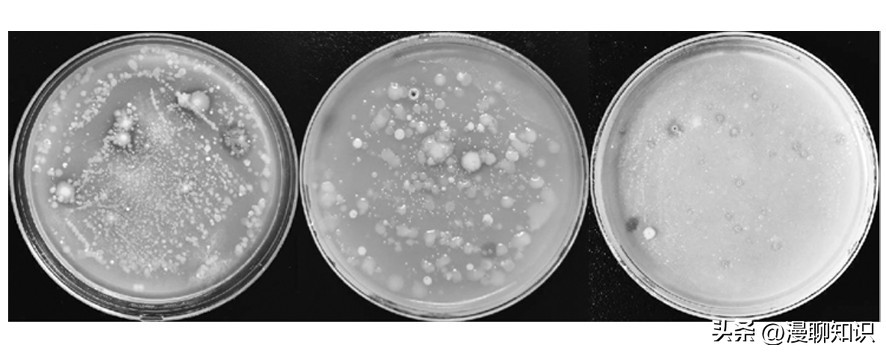
几丁质在水产的作用与功效,几丁质酶的本质

在阅读此文前,诚邀您请点点右上方的“关注”,既方便您进行讨论与分享,还能及时阅读最新内容,感谢您的支持。
几丁质酶降解几丁质可以产生高附加值的几丁寡糖、几丁单糖及其衍生物,这些酶解产物具有抑菌、诱导植物抗病性和促进植物生长等生物活性;此外在农业生产上,几丁质酶还具有生物防治的应用潜力,可以作为生物杀虫剂和抗真菌药物用来防治含有几丁质的有害致病生物,如昆虫、线虫和真菌;几丁质及其降解产物还可以制成地膜,这类地膜不易伸缩,在保证水分的同时可保证强度,还可以被微生物降解,不易污染环境。
因此,几丁质酶在农业等领域具有巨大的应用潜力。

细菌是环境中几丁质的主要降解者之一,也是被研究最多的微生物。
目前已经发现的产几丁质酶细菌很多,其中比较常见的有气单胞菌属(Aeromonas)、沙雷氏菌属(Serratia)、弧菌属(Vibrio)和芽胞杆菌属(Bacillus)等。
绝大部分细菌产几丁质酶的能力不够理想,使产业化的几丁质酶价格昂贵,难以实现商业应用。
因此,从自然界中分离筛选不同来源的产几丁质酶菌株,可为产几丁质酶微生物资源的开发和应用提供参考。
细菌16S rRNA序列分析是分子生态学领域的一项重要技术,被广泛应用于微生物的分类、鉴定以及群落研究,由于该技术具有高效、方便、准确、快捷等特点,使其在细菌鉴定和野生菌株的归属等方面具有广泛的应用。

淡水湖渔场中的鱼类、藻类、浮游动植物等种类丰富,是几丁质的重要来源,这些高分子有机物几丁质需要湖泊底泥中存在相应的产几丁质酶细菌分泌相应的胞外几丁质酶来进行降解并利用,目前,来自淡水湖底泥中的产几丁质酶菌株的相关研究较少。
本研究通过胶体几丁质筛选培养基从环洞庭湖的4个淡水湖渔场底泥中筛选分离得到26株产几丁质酶菌株,采用DNS法测定几丁质酶活以了解菌株的产酶量情况。
并对26株菌的16S rRNA基因扩增产物进行测定,对所测序列进行同源性分析和系统发育树的构建,以鉴定其分类地位,进而了解菌株的分布情况。
该研究结果对于从淡水湖渔场底泥原位环境中筛选并鉴定具有潜在益生作用的功能微生物具有重要意义。

材料与方法
材料样品来源
样品采自环洞庭湖4个淡水湖渔场(汉寿县安乐湖、澧县北民湖、华容县东湖和津市西湖)的表层底泥。
4个淡水湖与洞庭湖的分布关系如图1所示。
主要试剂与仪器设备
几丁质、N-乙酰葡糖胺,EasyTaq® DNA Polymerase AP111-02、EasyPure® Bacteria Genomic DNA Kit EE161-11、GelStain GS101-02,其他试剂均为分析纯。
Hirayama灭菌器;真空冷冻干燥机;酶标仪;基因扩增仪。

培养基(质量分数,%)
①改良Luria-Bertani液体培养基:蛋白胨1,酵母粉0.5,NaCl 1,蒸馏水配制,pH 7.5,115 ℃高压蒸气灭菌30 min。
液体培养基中加入1.3%琼脂粉即为改良LB固体培养基;②胶体几丁质筛选培养基:蛋白胨0.3,KH2PO4 0.03,K2HPO4·3H2O 0.07,FeSO4·7H2O 0.002,MgSO4 0.05,ZnSO4·7H2O 0.001,胶体几丁质0.3,琼脂粉1.6,蒸馏水配制,pH 7.5,115 ℃高压蒸气灭菌30 min; ③胶体几丁质发酵培养基:蛋白胨0.2,葡萄糖0.1,酵母粉0.2,KH2PO4 0.03,K2HPO4·3H2O 0.07,FeSO4·7H2O 0.002,MgSO4 0.05,ZnSO4·7H2O 0.001,胶体几丁质0.3,蒸馏水配制,pH 7.5,115 ℃高压蒸气灭菌30 min。

图1 环洞庭湖的4个淡水湖渔场的分布示意图
方法
胶体几丁质的制备
称取10 g几丁质粉末,缓慢加入200 mL浓盐酸中,使之充分溶解。
28 ℃,180 r/min振荡约1.5 h至液体为红棕色。
将溶液加入2.5 L冷的蒸馏水中,快速搅拌混匀,4 ℃静置过夜使胶体几丁质全部析出。
4 ℃,5 000 r/min离心20 min收集析出的胶体几丁质,并用冷的蒸馏水反复清洗沉淀,直至pH大于5.0。
用200 mL去离子水重悬沉淀,制成胶体几丁质溶液,4 ℃保存。
使用真空冷冻干燥机通过干重法测定胶体几丁质浓度:取1 mL胶体几丁质溶液于离心管中,置于真空冷冻干燥机中冻干去除水分。
随后用含有胶体几丁质*干粉冻**的离心管重量减去离心管空管的重量,得到1 mL胶体几丁质溶液中胶体几丁质的含量,进而得到胶体几丁质的浓度。

产几丁质酶菌株的筛选
首先采用稀释涂布平板法对底泥中的产酶菌株进行筛选。
取10 g底泥样品加入三角瓶中(含50颗玻璃珠,90 mL无菌水),28 ℃、180 r/min振荡3 h, 室温静置1 h后取上清液,并对上清液进行梯度稀释 (10-1~10-6),每个梯度取100 μL样品涂布胶体几丁质筛选平板,28 ℃倒置培养1~2周。
挑取有透明圈的菌株于改良LB固体培养基上划线分离,挑取单菌落于改良LB液体培养基中28 ℃180 r/min培养1~2 d备用。
采用点种法进一步确定菌株的几丁质酶活性。
取2 μL纯化后的菌液(OD600约为1.0)点种到胶体几丁质筛选平板上,28 ℃培养5 d后,测定透明圈和菌落直径。
最后对有明显透明圈的菌株进行保藏和摇瓶发酵。
以1%(体积分数)的接种量将OD600约为1.5的新鲜菌液接入装有50 mL胶体几丁质发酵培养基的250 mL锥形瓶中,28 ℃、180 r/min培养3 d, 测定发酵液中几丁质酶活。

几丁质酶活测定
以胶体几丁质为底物,通过DNS法测定还原糖的含量计算几丁质酶活,测定步骤见参考文献,并进行细微改动。
①DNS试剂的配制:制成甲液:结晶苯酚溶于NaOH溶液中,加入蒸馏水稀释,再加入亚硫酸氢钠;制成乙液:将酒石酸钾钠溶于NaOH溶液中,再加入3, 5-二硝基水杨酸溶液。
将甲液和乙液混合,隔水加热至45 ℃,并不停搅拌即得黄色试剂,储存于棕色瓶中室温放置7~10 d后使用;②N-乙酰葡糖胺标准曲线的制作:分别取4 μmol/mL N-乙酰葡糖胺溶液0.00、66.00、132.00、198.00、264.00、330.00、396.00、462.00、528.00、594.00、660.00 μL于1.5 mL离心管中,用蒸馏水补足至660 μL。
混匀后得到一组浓度为0.00、0.40、0.80、1.20、1.60、2.00、2.40、2.80、3.20、3.60、4.00 μmol/mL的N-乙酰葡糖胺溶液。
分别加入DNS试剂300 μL,混匀后,于100 ℃水浴锅中温浴10 min, 室温冷却5 min, 13 000 r/min离心5 min, 取200 μL上清液于550 nm波长下测定吸光值。
以N-乙酰葡糖胺浓度为横坐标,校正吸光值为纵坐标,绘制标准曲线;③发酵液几丁质酶活测定:几丁质酶活测定采用DNS法。

取发酵液于2 mL离心管中,13 000 r/min离心5 min, 取上清液进行酶活测定,以蒸馏水为空白对照组。
在660 μL溶液中加入1%(体积分数)胶体几丁质,混匀后28 ℃,180 r/min反应4 h。
随后加入300 μL DNS试剂终止反应,并立即放入水溶锅中100 ℃温浴10 min, 室温冷却5 min后,13 000 r/min离心5 min, 取200 μL上清液测定OD550。
根据样品校正吸光值和N-乙酰葡糖胺标准曲线求得样品中还原糖的含量,并根据酶活定义得到样品几丁质酶活。
酶活单位(U)定义为在一定条件下,每小时催化产生1 μmol还原糖所需的酶量(mL)。

16S rRNA基因序列扩增
采用EasyPure® Bacteria Genomic DNA Kit(EE161-11),按说明书提取细菌基因组DNA,以细菌基因组DNA为模板,使用通用引物27F(5′-AGAGTTTGATCMTGGCTCAG-3′,M为A或C)和1492R(5′-TACGGYTACCTTGTTACGACTT-3′,Y为C或T),进行16S rRNA基因序列的扩增。
取10 μL PCR产物进行1%琼脂糖凝胶电泳检测。
16S rRNA基因序列比对与系统进化树构建
PCR扩增产物送至擎科生物科技有限公司进行基因测序,测序结果通过Nucleotide BLAST与GenBank和Eztaxon数据库中的序列进行同源性比对。
在初步确定系统发育上的亲缘关系后,选择近缘种进行系统发育分析。
将菌株及其近缘种的16S rRNA基因序列通过MEGA-7的Clutal W程序进行比对,在MEGA-7中使用邻接法构建系统发育树。
用靴值分析(1 000个重复)来评估进化树的拓扑关系,并使用Jukes和Cantor提出的模型对进化距离进行计算。

结果与分析
产几丁质酶菌株的筛选
稀释涂布平板法初筛
将从环洞庭湖淡水湖渔场采集到的表层底泥样品通过稀释涂布平板法进行产几丁质酶菌株的筛选。
通过观察,选取胶体几丁质筛选平板上有明显透明圈的菌株进行划线分离。
图2 菌株在胶体几丁质筛选 平板上形成的透明圈
点种法复筛
初筛得到的菌株经扩大培养后,取处于对数生长期的菌液点种于胶体几丁质筛选平板上进行复筛,共获得26株透明圈与菌落直径比大于1.0的菌株。
在通常情况下,平板上透明圈与菌落的直径比可作为快速判断菌株产酶能力高低的依据,但平板扩散筛选不能准确、定量地反映菌体生长情况和产酶能力,因此需要进一步的摇瓶发酵,通过测量发酵液酶活来确定菌株的产酶能力。

摇瓶发酵
经平板筛选后,选择来自汉寿县安乐湖表层底泥样品中的13株菌(A1~A13)、澧县北民湖表层底泥样品中的5株菌(B1~B5)、华容县东湖表层底泥样品中的7株菌(D1~D7)和津市西湖表层底泥样品中的1株菌(W1),共26株菌进行摇瓶发酵。
由图3可知,来自安乐湖的13株菌中,产酶量最高的菌株为A3,该菌株培养3 d后的发酵液酶活为(0.54±0.01) U/mL;来自北民湖的5株菌中,产酶量最高的菌株为B3,该菌株培养3 d后的发酵液酶活为(0.47±0.02) U/mL;来自东湖的7株菌中,产酶量最高的菌株为D6,该菌株培养3 d后的发酵液酶活为(0.43±0.01) U/mL;来自津市西湖的菌株W1培养3 d后的发酵液酶活为(0.69±0.02) U/mL。
表1 产几丁质酶菌株在胶体几丁质筛选平板上的透明圈与菌落直径比
|
菌株编号 |
菌落直 径/cm |
透明圈直 径/cm |
透明圈直径/ 菌落直径 |
|
A1 |
1.46 |
2.33 |
1.60 |
|
A2 |
1.19 |
1.70 |
1.43 |
|
A3 |
1.56 |
2.21 |
1.42 |
|
A4 |
1.47 |
2.03 |
1.38 |
|
A5 |
1.57 |
2.01 |
1.28 |
|
A6 |
1.85 |
2.28 |
1.23 |
|
A7 |
1.78 |
2.14 |
1.20 |
|
A8 |
1.57 |
1.89 |
1.20 |
|
A9 |
1.85 |
2.10 |
1.14 |
|
A10 |
1.63 |
1.83 |
1.12 |
|
A11 |
1.43 |
1.60 |
1.12 |
|
A12 |
3.79 |
4.16 |
1.10 |
|
A13 |
2.32 |
2.46 |
1.06 |
|
B1 |
2.22 |
2.60 |
1.17 |
|
B2 |
2.03 |
2.32 |
1.14 |
|
B3 |
1.89 |
2.14 |
1.13 |
|
B4 |
1.32 |
1.46 |
1.11 |
|
B5 |
2.20 |
2.51 |
1.14 |
|
D1 |
2.05 |
2.56 |
1.25 |
|
D2 |
2.03 |
2.47 |
1.22 |
|
D3 |
1.56 |
1.88 |
1.21 |
|
D4 |
1.68 |
2.01 |
1.20 |
|
D5 |
1.47 |
1.73 |
1.18 |
|
D6 |
4.30 |
4.91 |
1.14 |
|
D7 |
2.63 |
2.91 |
1.11 |
|
W1 |
1.54 |
1.81 |
1.18 |
注:A:汉寿县安乐湖;B:澧县北民湖;D:华容县东湖;W:津市西湖
产几丁质酶菌株的分子鉴定
从4个淡水湖渔场表层底泥中筛选分离到26株产几丁质酶菌株,提取26株产几丁质酶菌株的基因组DNA,利用通用引物对细菌16S rRNA基因进行扩增。
电泳结果如图4所示,PCR扩增产物大小均在1 500 bp左右,与预期片段大小相符。
对26株产几丁质酶菌株的16S rRNA基因进行测序,并将序列提交GenBank注册,获得序列号(Accession number)。
基于16S rRNA基因序列可对物种之间的同源性进行分析,相似性小于98%,一般可以认为属于不同种;相似性小于93%~95%,一般可以认为属于不同属。
菌株的16S rRNA基因序列比对信息见表2,26株产几丁质酶菌株与其相关的有效命名的典型菌株的16S rRNA基因序列最大相似性在96.81%~99.71%之间,说明此26株菌与其相似性最大的有效命名的典型菌株归属于同一属。

26株产几丁质酶菌株属于细菌域的2个纲(γ-变形菌纲(γ-Proteobacteria)和芽胞杆菌纲(Bacilli))的4个科(莫拉氏菌科(Moraxellaceae)、假单胞菌科(Pseudomonadaceae)、芽胞杆菌科(Bacillaceae)和芽胞杆菌目位置未定科(Bacillales Family XII. Incertae Sedis)),其中Bacilli占优势(16株,61.5%),其次是γ-Proteobacteria(10株,38.5%)。
Bacilli中Bacillaceae占优势(14株,87.5%),其次是Bacillales Family XII. Incertae Sedis(2株,12.5%);γ-Proteobacteria中Moraxellaceae占优势(9株,90%),其次是Pseudomonadaceae(1株,10%)。

图3 分离自4个淡水湖渔场表层底泥的26 株菌的发酵液几丁质酶活

图4 产几丁质酶菌株16S rRNA基因片段扩增结果
M:Trans 2K® Plus II DNA分子标记
M: Trans 2K® Plus II DNA Marker
表2 产几丁质酶菌株的16S rRNA基因序列的比对信息
|
纲/科 |
菌株编号 |
相似度最高的模式菌株 |
相似性/% |
完整性/% |
|
γ-Proteobacteria (10/26) |
||||
|
Moraxellaceae (9) |
A4 (OM956828) |
Acinetobacter tandoii DSM 14970T (KE007359) |
97.84 |
100.00 |
|
A5 (OM956827) |
Acinetobacter tandoii DSM 14970T (KE007359) |
98.33 |
100.00 |
|
|
A12 (OM959224) |
Acinetobacter tandoii DSM 14970T (KE007359) |
97.98 |
100.00 |
|
|
B1 (OM959236) |
Acinetobacter guerrae AC 1271T (KX870878) |
97.03 |
92.30 |
|
|
B2 (OM959238) |
Acinetobacter tandoii DSM 14970T (KE007359) |
97.14 |
100.00 |
|
|
D2 (OM959329) |
Acinetobacter soli CIP 110264T (APPU01000012) |
99.10 |
100.00 |
|
|
D3 (OM959332) |
Acinetobacter guerrae AC 1271T (KX870878) |
96.81 |
92.30 |
|
|
D5 (OM959357) |
Acinetobacter tandoii DSM 14970T (KE007359) |
97.07 |
100.00 |
|
|
W1 (OM959512) |
Acinetobacter tandoii DSM 14970T (KE007359) |
98.81 |
100.00 |
|
|
Pseudomonadaceae (1) |
B3 (OM959239) |
Pseudomonas neuropathica P155T (LR797591) |
99.43 |
84.40 |
|
Bacilli (16/26) |
||||
|
Bacillaceae (14) |
A1 (OM956823) |
Bacillus cereus ATCC 14579T (AE016877) |
99.45 |
100.00 |
|
A2 (OM956825) |
Bacillus cereus ATCC 14579T (AE016877) |
99.51 |
100.00 |
|
|
A3 (OM956829) |
Bacillus cereus ATCC 14579T (AE016877) |
99.24 |
100.00 |
|
|
A6 (OM956830) |
Bacillus cereus ATCC 14579T (AE016877) |
99.31 |
100.00 |
|
|
A7 (OM957538) |
Bacillus cereus ATCC 14579T (AE016877) |
99.04 |
100.00 |
|
|
A8 (OM957535) |
Bacillus paranthracis Mn5T (MACE01000012) |
98.96 |
100.00 |
|
|
A9 (OM957541) |
Bacillus wiedmannii FSL W8-0169T (LOBC01000053) |
98.76 |
100.00 |
|
|
A10 (OM957547) |
Bacillus albus N35-10-2T (MAOE01000087) |
99.45 |
100.00 |
|
|
A11 (OM957552) |
Bacillus toyonensis BCT-7112T (CP006863) |
98.97 |
100.00 |
|
|
A13 (OM959227) |
Bacillus cereus ATCC 14579T (AE016877) |
99.31 |
100.00 |
|
|
B4 (OM959322) |
Bacillus paramycoides NH24A2T (MAOI01000012) |
98.97 |
100.00 |
|
|
B5 (OM959314) |
Bacillus cereus ATCC 14579T (AE016877) |
99.24 |
100.00 |
|
|
D1 (OM959326) |
Bacillus albus N35-10-2T (MAOE01000087) |
98.90 |
100.00 |
|
|
D4 (OM959345) |
Bacillus altitudinis 41KF2bT (ASJC01000029) |
98.82 |
100.00 |
|
|
Bacillales Family XII. Incertae Sedis (2) |
D6 (OM959372) |
Exiguobacterium mexicanum 8NT (AM072764) |
99.71 |
93.90 |
|
D7 (OM959389) |
Exiguobacterium profundum 10CT (AY818050) |
99.52 |
99.10 |
产几丁质酶菌株的系统发育分析
16S rRNA基因序列比对结果显示,26株菌中有11株与其相似性最大有效命名的典型菌株的16S rRNA基因序列相似性≤98.9%,存在一定的遗传差异。
因此,基于16S rRNA基因序列对这11株菌进行进一步的系统发育分析,以确定其分类地位。
其中,Moraxellaceae的8株菌的系统发育树如图5所示,菌株A4和A12在不动杆菌属簇内形成了一个独立的分支,与有效命名的典型菌株坦氏不动杆菌(Acinetobacter tandoii) DSM 14970T有较近的亲缘关系,且两株菌与其系统发育关系最密切的有效命名的典型菌株的16S rRNA基因序列相似性均小于98%,有可能是潜在的新种。
菌株B1、B2和D5在不动杆菌属簇内形成了一个独立的分支,与有效命名的典型菌株莫德斯托斯不动杆菌(Acinetobacter modestus) NIPH 236T有较近的亲缘关系,且3株菌与其系统发育关系最密切的有效命名的典型菌株的16S rRNA基因序列相似性均小于98%,有可能是潜在的新种;菌株A5和D3分别在不动杆菌属簇内形成了一个独立的分支,与有效命名的典型菌株Acinetobacter tandoii DSM 14970T有较近的亲缘关系,其中菌株D3与其系统发育关系最密切的有效命名的典型菌株的16S rRNA基因序列相似性小于97%,有可能是潜在的新种;菌株W1与有效命名的典型菌株Acinetobacter tandoii DSM 14970T聚为不动杆菌属簇内的同一分支,说明两者亲缘关系最近。

图5 分离自4个淡水湖渔场底泥中的8株Moraxellaceae的产几丁质酶菌株的系统发育树
括号中的序号表示菌株16S rRNA基因序列在GenBank中的序列号;分支点上的数字为自展支持率(%);标尺表示每个核苷酸位置有0.002个核苷酸替换,表示相似性百分比;下同
Bacillaceae的3株菌的系统发育树如图6所示,菌株A9和D1在芽胞杆菌属簇内形成了一个独立的分支,与有效命名的典型菌株维德曼芽胞杆菌(Bacillus wiedmannii) FSL W8-0169T和白色芽胞杆菌(Bacillus albus) N35-10-2T有较近的亲缘关系;菌株D4在芽胞杆菌属簇内形成了一个独立的分支,与有效命名的典型菌株高地芽胞杆菌(Bacillus altitudinis) 41KF2bT有较近的亲缘关系。
综上基于16S rRNA基因序列的细菌鉴定可初步确定菌株的分类地位,但菌株分类地位的最终确定还需要进一步的多相分类鉴定。

产几丁质酶菌株的分布情况
从4个淡水湖渔场表层底泥中筛选到的产几丁质酶菌株的分布情况如图7所示,50%的菌株来自汉寿县安乐湖表层底泥,且13株产几丁质酶菌株(A1~A13)中有3株属于变形菌门的不动杆菌属,其他10株属于厚壁菌门的芽胞杆菌属;19%的菌株来自澧县北民湖表层底泥,且5株产几丁质酶菌株(B1~B5)中有3株属于变形菌门的不动杆菌属(2株)和假单胞菌属(1株),其他2株属于厚壁菌门的芽胞杆菌属;27%的菌株来自华容县东湖表层底泥,且7株产几丁质酶菌株(D1~D7)中有3株属于变形菌门的不动杆菌属,其他4株属于厚壁菌门的芽胞杆菌属(2株)和微小杆菌属(2株);4%的菌株来自津市西湖表层底泥,且此株产几丁质酶菌株(W1)属于变形菌门的不动杆菌属。
结果表明,分离得到的26株产几丁质酶细菌在4个淡水湖渔场表层底泥中的分布情况为安乐湖>东湖>北民湖>西湖;26株菌来自厚壁菌门(16株,61.5%)和变形菌门(10株,38.5%)两大类群的4个属,分别是芽胞杆菌属(14株,53.8%),不动杆菌属(9株,34.6%),微小杆菌属(2株,7.7%)和假单胞菌属(1株,3.8%)。

图6 分离自4个淡水湖渔场底泥中的3株Bacillaceae的产几丁质酶菌株的系统发育树

图7 分离自4个淡水湖渔场底泥中的产几丁质酶菌株的分布情况
A:产几丁质酶菌株的数量分布情况;B:基于门水平的分布情况;C:基于属水平的分布情况
中国是几丁质的产量大国,其相关产业正成长为一个重要的高分子产业。
通过几丁质酶将几丁质降解成低分子量的产物是回收几丁质的一种方法,该方法具有很多优点,如生产工艺简单、反应条件温和、降解产物容易控制、产物活性高、无污染等。
因此,对几丁质酶资源的挖掘有利于几丁质及其降解产物的应用。
随着现代分子生物学技术的发展,可以直接从环境中克隆出几丁质酶基因构建产几丁质酶的工程菌,但是从自然界中分离野生的产几丁质酶菌株仍是不可替代的工作。

有研究从食虫蝙蝠的粪便中分离得到了28株菌,其中70%具有几丁质降解活性,并具有抗植物病原真菌的活性;Liu等从南极洲菲尔德斯半岛海洋沉积物中分离得到一株适冷产几丁质酶菌株,其胞外粗几丁质酶对植物病原真菌具有显著抑制效果;Subramanian等从虾废物处理场分离得到一株产几丁质酶的无色杆菌,其几丁质酶可降解贝类废弃物,降解产物可作为饲料用于水产养殖业。
本研究从环洞庭湖的4个淡水湖渔场表层底泥中筛选分离得到的26株产几丁质酶菌株的几丁质酶活在0.07~0.69 U/mL之间。
不同的菌株酶活差别较大,与其他研究相比,此26株菌的产酶量一般。
如在浙江省台州市剑门港海区海底淤泥中筛选分离得到的5株产几丁质酶菌株,单位换算后菌株几丁质酶活在22.20~38.40 U/mL之间;从湖北武汉地区虾壳堆积土壤中筛选分离得到的一株产几丁质酶的无色杆菌,单位换算后菌株几丁质酶活为0.25 U/mL;从水稻田土中筛选分离得到的产几丁质酶菌株,单位换算后菌株几丁质酶活约为8.40 U/mL;从阿尔及利亚半干旱土壤中分离出来的一株产几丁质酶的链霉菌C9,单位换算后菌株几丁质酶活约为3.48 U/mL。
尽管从淡水湖底泥中筛选得到的26株菌的产酶量一般,但是对不同自然条件下的产几丁质酶菌株的筛选,有助于挖掘产几丁质酶菌株的生物资源,扩宽对其分布情况的认识,并为产几丁质酶菌株的应用提供参考。

产几丁质酶菌株广泛分布于不同细菌门类中,最多的是变形菌门(Proteobacteria)和厚壁菌门(Firmicutes),其中芽胞杆菌属、假单胞菌属和不动杆菌属等都有分布。
本研究分离自4个淡水湖底泥中的26株产几丁质酶菌株与其相似性最大的有效命名的典型菌株归属于同一属,其中7株产几丁质酶菌株有可能是潜在的新种,分类地位的最终确定还需要进一步的多相分类鉴定。
26株产几丁质酶菌株均分布在变形菌门和厚壁菌门,与上述研究一致。
本研究中的菌株除了分布于芽胞杆菌属、假单胞菌属和不动杆菌属外,还在微小杆菌属中有分布。
不同来源的产几丁质酶菌株的发现有利于几丁质酶资源的挖掘,并为新型几丁质酶和高产几丁质酶菌株的进一步研究提供了可能。

本研究通过稀释涂布平板法、点种法和摇瓶发酵法从环洞庭湖的4个淡水湖渔场表层底泥中筛选分离得到26株产几丁质酶菌株,几丁质酶活在0.07~0.69 U/mL之间。
基于16S rRNA基因序列比对和系统发育分析对分离自4个淡水湖底泥中的26株产几丁质酶菌株进行了初步鉴定,表明26株菌与其相似性最大的有效命名的典型菌株归属于同一属,其中菌株A4、A5、A12、B1、B2、D3和D5有可能是潜在的新种。
26株产几丁质酶菌株有50%来自汉寿县安乐湖表层底泥,19%来自澧县北民湖表层底泥,27%来自华容县东湖表层底泥,4%来自津市西湖表层底泥。
26株产几丁质酶菌株均分布在变形菌门和厚壁菌门两大类群的4个属,分别是芽胞杆菌属(14株,53.8%)、不动杆菌属(9株,34.6%)、微小杆菌属(2株,7.7%)和假单胞菌属(1株,3.8%)。
本研究的相关结果揭示了分离自环洞庭湖的4个淡水湖渔场底泥中的产几丁质酶菌株的初始产酶情况和分布特点,为产几丁质酶菌株资源的开发和应用奠定了提供了参考。
Tsurkan MV,Voronkina A,Khrunyk Y,et al.Progress in chitin analytics[J].Carbohydrate Polymers,2021,252:117204.
Liaqat F,Eltem R.Chitooligosaccharides and their biological activities:A comprehensive review[J].Carbohydrate Polymers,2018,184:243-259.
Berini F,Katz C,Gruzdev N,et al.Microbial and viral chitinases:Attractive biopesticides for integrated pest management[J].Biotechnology Advances,2018,36(3):818-838.